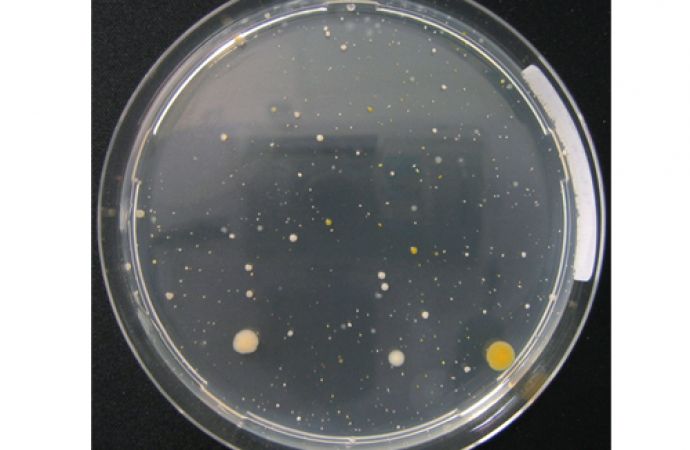

Von Nora Erlacher, ProWaTech AG, Schweiz, und Herbert Hauser, Hauser + Walz GmbH, Schweiz
Die Spülung der Werkstücke in der Oberflächenbranche mit Wasser zwischen respektive nach dem nasschemischen Prozessschritt beeinflusst direkt die Beschichtungsqualität. Der Einsatz qualitativ hochwertigen Spülwassers und hoher Quantitäten zur Erzielung höchster Beschichtungsqualitäten steht konträr zu dem steigenden Kostendruck, gerade in Hochlohnländern. Hinzu kommen gesetzliche Anforderungen an umweltschonende und somit abwasser- und abfallarme Prozesse in der Oberflächentechnik (Stand der Technik). Wie die Spülwassermenge berechnet wird, wie der Spüleffekt verstärkt wird und welche Anforderungen an die Spülwasserqualität heutzutage gestellt werden, soll der erste Teil dieses Beitrages beantworten.
Rinsing can be Calculated and Need not be a Problem
Aqueous rinsing of components after wet chemical processing stages in Surface Finishing can directly influence coating quality. Use of high purity water in liberal quantities to achieve high-quality rinsing, runs counter to cost pressures, not least in high-wage economies. Also to be considered are environmental legislative requirements and their impact on effluent and solid waste emissions technology in the Surface Finishing industry (State of Art). How to calculate the required volumes of rinsewater and how to enhance the rinsing action and what requirements are currently imposed on rinsewater quality, are issues addressed in the first part of this series.
Grundlagen der Spültechnik
Das Spülen hat zwei Aufgaben. Erstens eine chemie- und fleckenfreie Spülung der veredelten Werkstücke und zweitens eine Reduktion des Eintrages von Prozesslösung in eine nachfolgende Prozesslösung, was häufig unterschätzt wird.
Wasser dient in der Regel als Betriebsmittel für Spülprozesse der nasschemischen Oberflächenbehandlung. An der Phasengrenze der zu spülenden Werkstücke fest/flüssig beträgt die Fließgeschwindigkeit der Flüssigkeit an der Feststoffoberfläche gleich Null. Es bildet sich die so genannte Prandtl’sche Grenzschicht aus, in der eine laminare Strömung vorliegt. Die laminare Strömung auf der Oberfläche sorgt dafür, dass es kaum zum Abtransport von Stoffen durch Konvektion kommt. Dies hat fatale Folgen für den Spülprozess, bei dem die anhaftende Prozesslösung durch Spülwasser verdünnt werden soll. Die Prandtl’sche Grenzschicht ist unter anderem abhängig vom Oberflächenprofil (wie z. B. Rauheit) sowie Strömungsgeschwindigkeit in der Flüssigkeit.
Ein weiteres Model von Walther Nernst (Nobelpreisträger) beschreibt die Diffusionsvorgänge an der Grenzschicht fest/flüssig. Treibende Kraft für den Massetransport von der Oberfläche in die Flüssigkeit ist der Diffusionsgradient. Je höher der Konzentrationsunterschied zwischen der Lösung auf der Feststoffoberfläche und in der homogenen Flüssigkeit ist, desto höher ist der Massestrom und somit Abtransport von Ionen. Die Diffusion führt jedoch zu keinem Abtransport von zum Beispiel Partikeln. Temperaturerhöhung führt zwar zur Reduktion der beiden Grenzschichten, sie ist jedoch gegenüber einer Erhöhung der Anströmung der Oberfläche (Geschwindigkeit der Konvektion) deutlich teurer.
Verdünnungslehre
Das Spülen von Werkstücken stellt eine Verdünnung des verschleppten Flüssigkeitsfilmes auf der Oberfläche der Ware und deren Hilfseinrichtungen mit dem Spülwasser dar. Die verschleppte Flüssigkeitsmenge (V) mit der Konzentration an Chemikalien des Wirkbades (c0) wird beim Eintauchen in eine Spüle mit einer bestimmten Wassermenge (Q) verdünnt.
Als Maß für die Qualität der Spülung (V = Verdünnungsgrad) wird das dimensionslose Spülkriterium (R) definiert. Dies ist das Verhältnis der ursprünglichen Konzentration c0 im Prozessbad zu der Konzentration cn in der n-ten Spüle. Das Spülkriterium lässt sich aber auch als Verhältnis von eingesetzter Spülwassermenge zur Verschleppung bei gleicher Zeiteinheit berechnen. Bei mehreren Spülschritten handelt es sich um eine mathematische Reihe, bei der sich die einzelnen Spülkriterien multiplizieren. Gleichung 〈1〉 zeigt die Berechnung des Spülkriteriums für die Anzahl n-Spülen (Abb. 1):
Rn = c0/cn = (Q/V)n+1 -1 / ((Q/V) - 1) 〈1〉
mit (Q:V > 10:1)

Abb. 1: Stoffbilanz für n-fache Spülkaskaden
In erster Näherung kann man das Spülkriterium als Wassermenge Q geteilt durch Verschleppung V berechnen. Die Berechnung zeigt, dass beim Einsatz mehrerer Spülschritte, der Spülwasserbedarf bei gleichem Spülkriterium (der letzten Spüle in Relation zum Prozessbad) massiv abnimmt. Bei 1 l/h Verschleppung und erwünschtem Spülkriterium in Höhe von 5000 muss 5000 l/h Spülwasser in einer Fließspüle eingesetzt werden, jedoch nur 16,75 l/h bei einer dreifach durchflossenen Spülkaskade gemäß Gleichung 1.
Die jeweilige Elektrolytverschleppung ist die entscheidende Größe für die erforderliche Spülwassermenge, aber auch die Schadstoffbelastung für den Spülwasserkreislauf und die Abwasserbehandlung (Chemikalienbedarf, Schlammanfall). Daher ist es wichtig, die Verschleppung in den jeweiligen Prozessschritten zu erfassen. Diese hängt von vielen Faktoren ab, wie beispielsweise Oberflächengeometrie, Flächendurchsatz, Abtropfzeiten oder Viskosität der Flüssigkeit. Tabelle 1 zeigt einige typische Verschleppungen, die in der Praxis erfasst wurden.

Die Autoren legen für eine Galvanik mittlerer Anforderung folgende Spülkriterien fest:
- Vorbehandlung: 500 - 2000
- Abscheideelektrolyte: 2000 - 5000
- Nachbehandlung: 5000 - 20 000
Die Spülkriterien können je nach Anforderungen in der Praxis aber auch bis zu 2 Millionen betragen, um eine ausreichende Qualität der Spülung zu erzielen.
Präventive Maßnahmen
Die Elektrolytverschleppung stellt die alles entscheidende Größe dar. Zur Reduktion des Spülwasserbedarfes sollte die Verschleppung durch folgende Maßnahmen klein gehalten werden:
- Abspritzen über dem Prozessbad
- Wirkkonzentration im Prozessbad reduzieren
- Rückführung des Spülwassers in warm betriebene Prozessbäder
- Abtropfzeiten bei Gestellen: 10 s über dem Prozessbad
- Verschleppungsarme Gestelltechnik, zum Beispiel Kippvorrichtung bei Hohlware
- Massenware: 2x eine halbe Umdrehung der Trommeln über Prozessbad
- Einsatz von Drainagetrommeln oder Saug-Blas-Systemen für Trommeln
- Auf die Werkstücke angepasste Perforation der Trommeln
Beim Elektropolieren von Edelstahl wird in der Praxis nach dem Prozessbad eine leere Wanne eingesetzt, bei dem die benetzten Werkstücke nach dem Prozess minutenlang abtropfen können. Solch lange Abtropfzeiten führen jedoch bei fast allen anderen Prozessen zu Störungen, da die Oberfläche reaktiv ist (außer beim Elektropolieren).
Zur Erhöhung des Spülkriteriums beziehungsweise Erniedrigung des Spülwasserbedarfes bei gleichem Spülkriterium können – neben der bereits erwähnten Kaskadierung – folgende Spültechniken zum Einsatz kommen:
- Rekuperativspülen (Abb. 2): Ohne Spülwasserwechsel stellt sich eine Konzentration in der Spüle von 50 % in Relation vom Prozessbad ein (Badfolge 2-1-2). Diese Technik wird zum Beispiel beim Brünieren (Schwarzfärben von Stahl) eingesetzt, bei dem die Werkstücke zusätzlich vorgewärmt werden. Sie wird auch bei Edelmetall-Abscheidebädern eingesetzt, bei der keine Rückführung durch natürliche Badverdunstung möglich ist und gleichzeitig die Prozesslösung recht kostenintensiv in der Beschaffung ist.
- Mehrfachverwendung von Spülwasser (Abb. 3): Die Mehrfachverwendung wird sowohl beim Anodisieren wie auch in der Elektronik (Leiterplattenherstellung) erfolgreich eingesetzt. Sie hat zusätzlich den Vorteil, dass die Teile mit Prozesslösung aus Bad Nr. 3 vorgespült werden, bevor sie in dieses Prozessbad gelangen.

Abb. 2: Rekuperativspülen

Abb. 3: Mehrfachverwendung von Spülwasser
Unterstützung des Spüleffektes
Die Verdünnungslehre geht von einer Einstellung eines Gleichgewichtes aus. Für eine effiziente Spülung der Werkstücke ist in den Spülen die Fließgeschwindigkeit der Flüssigkeit zu erhöhen und für eine Erhöhung der Diffusion sind auch die Spülwasserqualität (niedrige Salzkonzentration) sowie die Temperatur und die Reaktionszeiten zu erhöhen. Die Geschwindigkeit wird durch Badumwälzung mittels Pumpen, Warenbewegung, Lufteinblasung, Schwalldüsen, mehrfaches Ein- und Ausfahren oder Spritzspültechnik erhöht. Abbildung 4 zeigt eine schematische Darstellung, wie Luftblasen, die an einem Sackloch vorbeiströmen, durch Über- und Unterdruck einen Flüssigkeitsaustausch bewirken. In Abbildung 5 sind einige Bauteilarten auf Gestellen zur Oberflächenbehandlung gezeigt.

Abb. 4: Strömungsverhalten von Luftblasen an einer Oberfläche mit Sackloch
 |
 |
 |
Abb. 5: Unterschiedliche Arten von Bauteilen auf Gestellen für die Oberflächenbehandlung; je nach Geometrie der Bauteile ist der Spüleffekt unterschiedlich, da unter anderem die Strömung der Spüllösung an der Bauteiloberfläche variiert (Quelle: Stalder AG/ Engelburg/Schweiz)
Mittlerweile wird auch die Sonografie (Ultraschalltechnik) zur Unterstützung des Spülprozesses eingesetzt. Ultraschall sind Druckwellen oberhalb der Hörfrequenz, bei der an der Phasengrenze fest/flüssig so hohe Drücke erzielt werden, dass Dampfblasen entstehen, die wieder kollabieren. Dabei entsteht ein so genannter Mikrojet (Anströmung der Oberfläche), die zu einem Abtransport von beispielsweise Ionen, Pigmente oder Emulsionen führen. Es kommen Frequenzen um 27 kHz zum Einsatz. Wichtig ist ein Abtransport der Verunreinigungen durch Spülwasseraustausch. Bei weichen Werkstoffen und längerer Einwirkzeit kann es aber zu Kavitation und somit Materialausbrüchen kommen.
In der Praxis wird das Volumen von Fließspülen ein- bis siebenmal pro Stunde umgewälzt. Zur Kreislaufführung und somit Einsparungen von etwa 95 % des Spülwasservolumens haben sich seit Jahrzehnten Ionenaustauscher bewährt. Eine abschließende Reinwasserspüle (Warmspüle) bei 50 °C bis 55 °C, die über einen separaten Ionenaustauscher oder Umkehrosmose im Kreislauf betrieben wird, ist heute für eine fleckenarme Trocknung Stand der Technik. Je nach Werkstück muss die Leitfähigkeit im Auslauf dieser Reinwasseranlage kleiner 5, 2 oder 1 µS/cm betragen. Bei Edelmetallelektrolyten wird zusätzlich vor den Prozessbädern mit Reinwasser (kleiner 2 µS/cm Leitfähigkeit) gespült.
Anforderungen an die Prozesswasserqualität
Die Anforderungen an die Spülwasserqualität sind so vielfällig wie die Branchen, in denen eine Oberflächenbehandlung eingesetzt wird. Neben der elektrischen Leitfähigkeit ist eine turnusmäßige Messung der Konzentration an Organika, gemessen als gesamter organischer Kohlenstoff (TOC) sowie die Messung von mesophilen aeroben Keimen (koloniebildende Einheiten, KBE) von Bedeutung. Nur entsprechend geschultes Personal und die Verwendung von speziellen Probenflaschen gewährleisten reproduzierbare Werte.
Abbildungen 6 und 7 zeigen ein unbewachsenes und bewachsenes Nährmedium (koloniebildende Einheiten, KBE/ml).

Abb. 6: Unbewachsenes Nährmedium
|
Abb. 7: Bewachsenes Nährmedium
|
In Tabelle 2 sind Konzentrationsbereiche aufgeführt, die in der Praxis über Jahre gemessen wurden und die in der Regel zu keinen Störungen der Prozesse geführt haben. In der vierten Zeile sind Anforderungen, die das Europäische Pharmakopöe (Arzneibuch) vorschreibt.

Trinkwasser, auch Stadt- oder Frischwasser genannt, stellt für viele Prozesse immer noch eine ausreichende Qualität dar. Auf der anderen Seite werden die Inhaltsstoffe und deren Anreicherung durch Ergänzung von Verdunstungsverlusten in Prozessbädern häufig unterschätzt. Beispiele hierfür sind Kalzium (Ausfällungen), Chloride (verschlechterte Streuung in Chromelektrolyten), Kieselsäure (Probleme beim Sealing von Aluminium), Huminstoffe (Partikel auf Leiterplatten) oder Mikroorganismen (Behinderung der Ni-PTFE-Dispersionsabscheidung).
Vermeidung von Mikroorganismen
Bei mikrobiologischen Anforderungen gilt der Grundsatz der Vermeidung der Bildung von Kleinstlebewesen im Prozesswasser, wie beispielsweise Bakterien, Pilze, Algen oder Flusskrebse. Präventive Maßnahmen sind niedriger TOC-Eintrag und niedrige Temperaturen, geringe Lichteinwirkung, Vermeidung von Wasserstillstand und Toträumen oder Siphons sowie turnusmäßiger Wasserwechsel, Wannenreinigung, Abtrocknung und gegebenenfalls Einsatz von Breitband-Bioziden. Entsprechende Reinigungs- und Wartungspläne für die Produktion sorgen für mehr Prozesssicherheit.
Die Entkeimung des Wassers durch UV-Strahlung bei 253,7 nm Wellenlänge gewinnt immer mehr an Bedeutung, da die Mikroorganismen keine Resistenzen bilden. Moderne UV-Strahler haben nach 12 000 Betriebsstunden noch 75 % Strahlerleistung. Die UV-Strahlung inaktiviert das Erbgut (DNS) der Mikroorganismen (Abb. 8).

Abb. 8: Schematische Darstellung der Entkeimung von Wasser durch UV-Strahlung.
Resümee
Die physikalischen und chemischen Grundlagen zur Phasengrenze fest/flüssig zeigen, dass eine effiziente Spülung der Werkstücke nur durch gezielte Unterstützung des Spülvorganges möglich ist. Die Anforderungen an die Wasserqualitäten sind vielfältig und steigen laufend. Nur durch Online-Messungen sowie turnusmäßige Prozesswasseruntersuchungen wird eine bessere Protokollierung und Rückverfolgbarkeit des Vorgangs Spülen erzielt.
Welche Spülfehler in der Praxis durch optimale Spülung vermieden werden können und welche Anlagentechnik zur Aufbereitung der Prozesswässer zur Verfügung steht, wird im zweiten und dritten Teil des Beitrages fortgesetzt.
- www.prowatech.ch
- www.hauserwalz.ch
DOI: 10.7395/2013/Hauser1_1